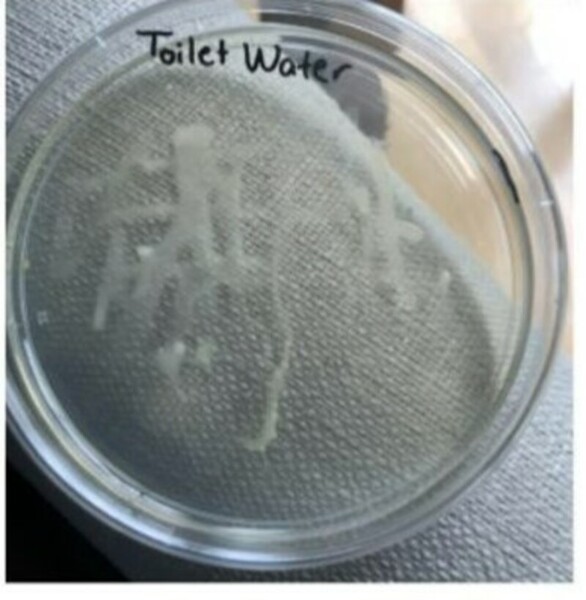
Effects of cleaning agents on bacterial growth on refrigerator surfaces

Anti-diabetic drugs like Metformin are known to increase gut permeability, and this has a negative impact on patient health. These authors hypothesized that this can be mitigated using purple sweet potato extract, which is high anthocyanin content, that feeds bacteria metabolism to decrease gut permeability.
Read More...